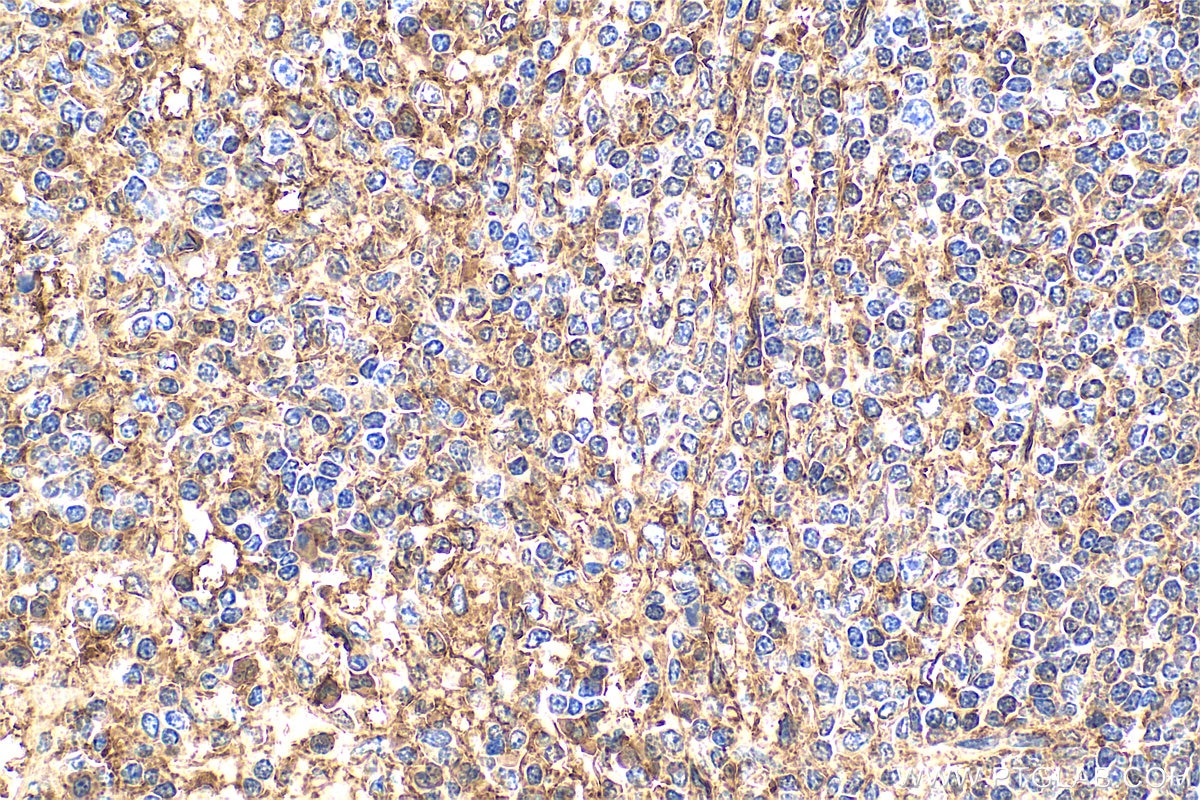
Immunohistochemistry (IHC) staining of human spleen tissue using Annexin V Polyclonal antibody (11060-1-AP)
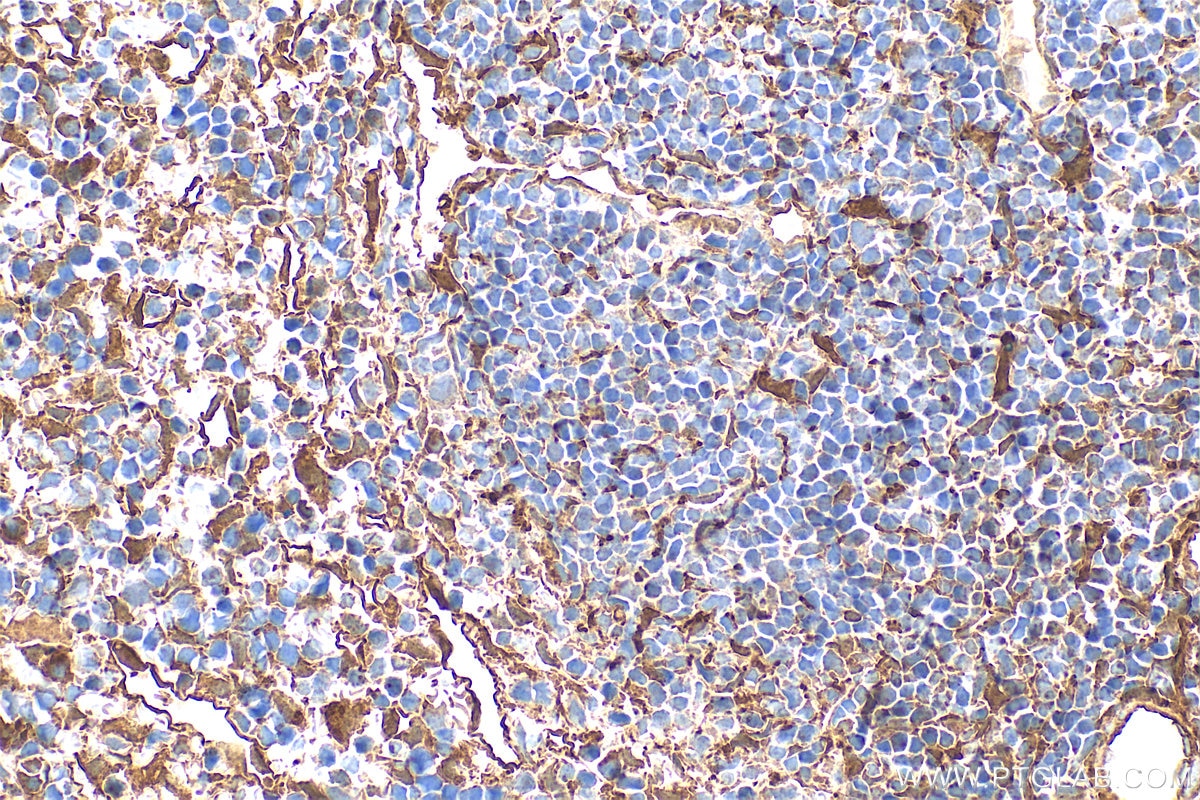
Immunohistochemistry (IHC) staining of mouse spleen tissue using Annexin V Polyclonal antibody (11060-1-AP)

Tested Applications
| Positive WB detected in | HEK-293T cells, A431 cells, C6 cells, HeLa cells, HepG2 cells, human heart tissue, human lung tissue, human placenta tissue, human skeletal muscle tissue, NIH/3T3 cells, pig heart tissue, pig liver tissue, K-562 cells, NIH?3T3 cells, C2C12 cells |
| Positive IP detected in | HeLa cells, mouse liver tissue |
| Positive IHC detected in | human spleen tissue, human placenta tissue, mouse spleen tissue Note: suggested antigen retrieval with TE buffer pH 9.0; (*) Alternatively, antigen retrieval may be performed with citrate buffer pH 6.0 |
| Positive IF/ICC detected in | HeLa cells |
| Positive FC (Intra) detected in | HeLa cells |
Recommended dilution
| Application | Dilution |
|---|---|
| Western Blot (WB) | WB : 1:5000-1:50000 |
| Immunoprecipitation (IP) | IP : 0.5-4.0 ug for 1.0-3.0 mg of total protein lysate |
| Immunohistochemistry (IHC) | IHC : 1:300-1:1200 |
| Immunofluorescence (IF)/ICC | IF/ICC : 1:200-1:800 |
| Flow Cytometry (FC) (INTRA) | FC (INTRA) : 0.25 ug per 10^6 cells in a 100 µl suspension |
| It is recommended that this reagent should be titrated in each testing system to obtain optimal results. | |
| Sample-dependent, Check data in validation data gallery. | |
Published Applications
| KD/KO | See 2 publications below |
| WB | See 26 publications below |
| IHC | See 9 publications below |
| IF | See 12 publications below |
| IP | See 1 publications below |
Product Information
11060-1-AP targets Annexin V in WB, IHC, IF/ICC, FC (Intra), IP, ELISA applications and shows reactivity with human, mouse, rat, pig samples.
| Tested Reactivity | human, mouse, rat, pig |
| Cited Reactivity | human, mouse, rat |
| Host / Isotype | Rabbit / IgG |
| Class | Polyclonal |
| Type | Antibody |
| Immunogen |
CatNo: Ag1538 Product name: Recombinant human ANXA5 protein Source: e coli.-derived, PET28a Tag: 6*His Domain: 1-320 aa of BC001429 Sequence: MAQVLRGTVTDFPGFDERADAETLRKAMKGLGTDEESILTLLTSRSNAQRQEISAAFKTLFGRDLLDDLKSELTGKFEKLIVALMKPSRLYDAYELKHALKGAGTNEKVLTEIIASRTPEELRAIKQVYEEEYGSSLEDDVVGDTSGYYQRMLVVLLQANRDPDAGIDEAQVEQDAQALFQAGELKWGTDEEKFITIFGTRSVSHLRKVFDKYMTISGFQIEETIDRETSGNLEQLLLAVVKSIRSIPAYLAETLYYAMKGAGTDDHTLIRVMVSRSEIDLFNIRKEFRKNFATSLYSMIKGDTSGDYKKALLLLCGEDD Predict reactive species |
| Full Name | annexin A5 |
| Calculated Molecular Weight | 36 kDa |
| Observed Molecular Weight | 36 kDa |
| GenBank Accession Number | BC018671 |
| Gene Symbol | Annexin V |
| Gene ID (NCBI) | 308 |
| RRID | AB_2057585 |
| Conjugate | Unconjugated |
| Form | Liquid |
| Purification Method | Antigen affinity purification |
| UNIPROT ID | P08758 |
| Storage Buffer | PBS with 0.02% sodium azide and 50% glycerol, pH 7.3. |
| Storage Conditions | Store at -20°C. Stable for one year after shipment. Aliquoting is unnecessary for -20oC storage. 20ul sizes contain 0.1% BSA. |
Background Information
Annexin A5 (ANXA5), is a member of the structurally related family of annexin proteins some of which have been implicated in membrane-related events along exocytotic and endocytotic pathways. Annexin 5 is a phospholipase A2 and protein kinase C inhibitory protein with calcium channel activity and a potential role in cellular signal transduction, inflammation, growth and differentiation. Annexin 5 has also been described as placental anticoagulant protein I, vascular anticoagulant-alpha, endonexin II, lipocortin V, placental protein 4 and anchorin CII.
Protocols
| Product Specific Protocols | |
|---|---|
| FC protocol for Annexin V antibody 11060-1-AP | Download protocol |
| IF protocol for Annexin V antibody 11060-1-AP | Download protocol |
| IHC protocol for Annexin V antibody 11060-1-AP | Download protocol |
| IP protocol for Annexin V antibody 11060-1-AP | Download protocol |
| WB protocol for Annexin V antibody 11060-1-AP | Download protocol |
| Standard Protocols | |
|---|---|
| Click here to view our Standard Protocols |
Publications
| Species | Application | Title |
|---|---|---|
Adv Sci (Weinh) Isolation and Comprehensive Analysis of Cochlear Tissue-Derived Small Extracellular Vesicles | ||
Nucleic Acids Res Short DNA/RNA heteroduplex oligonucleotide interacting proteins are key regulators of target gene silencing. | ||
Matrix Biol Proteome-wide and matrisome-specific atlas of the human ovary computes fertility biomarker candidates and open the way for precision oncofertility. | ||
Mol Cancer Res DNA Methyltransferase 3B-Mediated Intratumoral Heterogeneity and Therapeutic Targeting in Breast Cancer Recurrence and Metastasis | ||
Cell Death Dis Annexin A5 regulates hepatocarcinoma malignancy via CRKI/II-DOCK180-RAC1 integrin and MEK-ERK pathways.
| ||
Front Cell Dev Biol Time-Resolved Extracellular Matrix Atlas of the Developing Human Skin Dermis. |